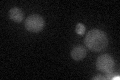
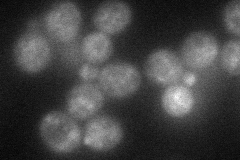
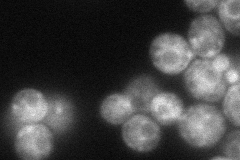
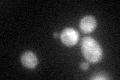

View description
Putative protein of unknown function
Localization:
Intensity:
Fold change:
Significance:
-
C’ GFP library in SD
cytosol21.53 -
N' NOP1pr-GFP in SD
cytosol55.3958 -
N' TEF2pr-mCherry in SD
cell periphery,vacuole53.0458 -
N' NATIVEpr-GFP in SD

punctate22.9935 -
N' TEF2pr-VC and Cyto-VN in SD

punctate38.1002 -
C’ GFP library in SD+DTT
cytosol24.281.12No -
C’ GFP library in SD+H2O2

cytosol22.81.05No -
C’ GFP library in Starvation Media

cytosol20.120.93No -
C’ GFP library on the background of Pup2-DaMP

cytosol -
C’ GFP library on the background of CCT mutant

cytosol23.32661.08292No
